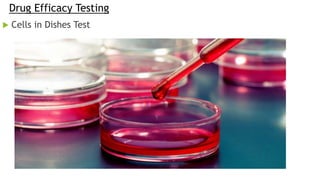
Drug Efficacy Testing
 Cells in Dishes Test

Microfluidics involves manipulating fluids in micrometer-sized channels for applications in drug testing and biomedical research. The document outlines the evolution of microfluidics and organ-on-a-chip technology, describing how these devices simulate human organ functions using living cells. Future developments aim to enhance personalized medicine and reduce animal testing by integrating patient-derived cells into these systems.